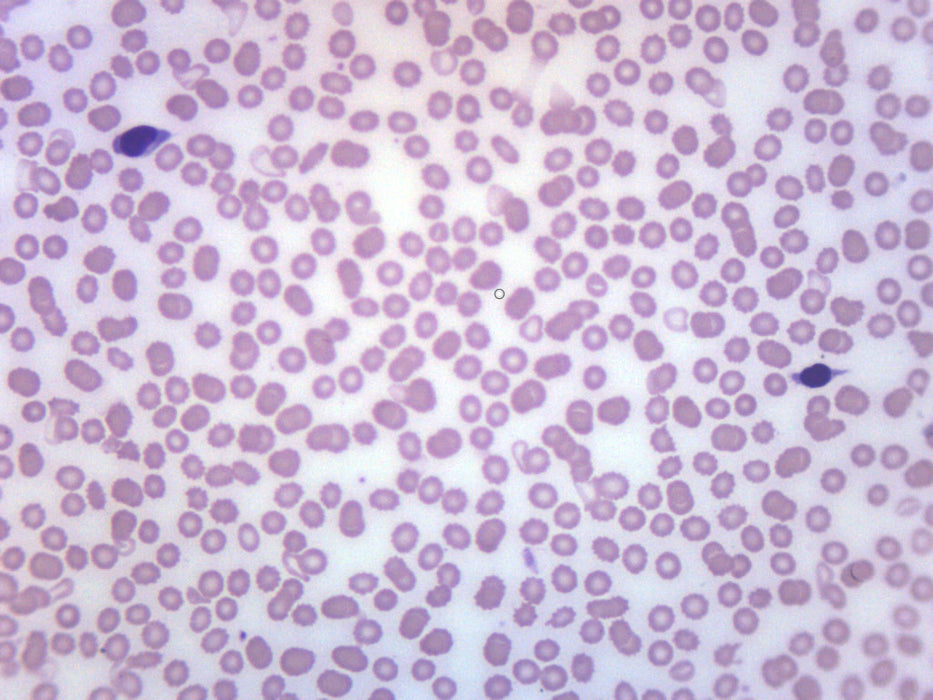

Human Blood Smear WR Stain - Prepared Microscope Slide - 75x25mm
SKU BS18001
Need it fast? Get it from a distributor here
or contact us for a list of options:
- Single, prepared slide with human blood smear. Stained with Wright's stain for better contrast between different blood types
- Slide measures 75mm wide and 25mm long
- Shows three main blood cell types - red, white & platelets
- Excellent for biology classrooms
- Arrives in a protective cardboard casing
Single, prepared microscope slide with human blood smear. Stained with Wright's stain for better contrast between different blood types. Shows three main types of blood cells- red cells, white cells and platelet cells. Excellent for biology instruction. Arrives in protective cardboard casing. Slide measures 75mm (3") wide, 25mm (1") long and 0.06" in height.
Slides are expertly prepared, and labeled for easy identification. All materials in Eisco Labs slides are completely inert and sealed in glass.
| Length | 1 |
| Weight | 0.1 |
| Width | 3 |
| Instructions | No instructions available online. Please contact us for further assistance. |
| High Resolution Image | Please register as a teacher or distributor to view and download high resolution images. |